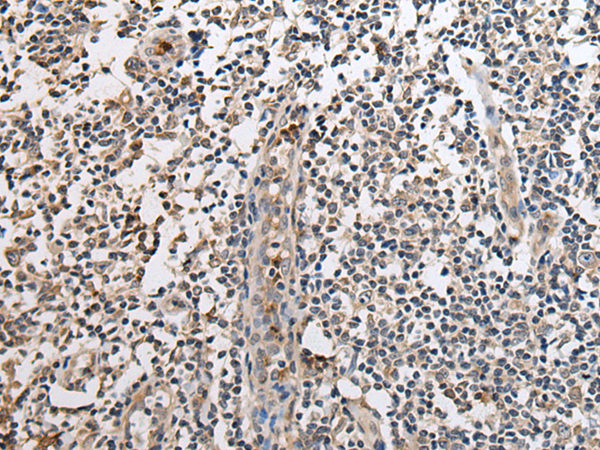
一抗

中文名稱:兔抗SLC8A1多克隆抗體
英文名稱: Anti-SLC8A1 rabbit polyclonal antibody
別 名: NCX1
相關類別: 一抗
儲 存: 冷凍(-20℃)
宿 主: Rabbit
抗 原: SLC8A1
反應種屬: Human, Mouse, Rat
標記物: Unconjugate
克隆類型: rabbit polyclonal
Background:
In cardiac myocytes, Ca(2+) concentrations alternate between high levels during contraction and low levels during relaxation. The increase in Ca(2+) concentration during contraction is primarily due to release of Ca(2+) from intracellular stores. However, some Ca(2+) also enters the cell through the sarcolemma (plasma membrane). During relaxation, Ca(2+) is sequestered within the intracellular stores. To prevent overloading of intracellular stores, the Ca(2+) that entered across the sarcolemma must be extruded from the cell. The Na(+)-Ca(2+) exchanger is the primary mechanism by which the Ca(2+) is extruded from the cell during relaxation. In the heart, the exchanger may play a key role in digitalis action. The exchanger is the dominant mechanism in returning the cardiac myocyte to its resting state following excitation.
Applications:
ELISA, IHC
Name of antibody:
SLC8A1
Immunogen:
Synthetic peptide of human SLC8A1
Full name:
solute carrier family 8 (sodium/calcium exchanger), member 1
Synonyms:
NCX1
SwissProt:
P32418
ELISA Recommended dilution:
500-1000
IHC positive control:
Human brain and human tonsil
IHC Recommend dilution:
25-100
技術規格


 購物車
購物車 幫助
幫助
 021-54845833/15800441009
021-54845833/15800441009